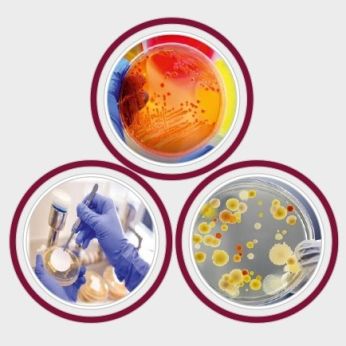

Accuprec Research Labs Pvt. Ltd.
Exhibitors
Information
Accuprec Research Labs is a Global service provider for various types of Regulatory testing services as well as Research based services required for Medical devices. Currently, we are working as an extended partner for more than 300+ Medical Devices companies globally. Further, we do provide Regulatory testing services as well as Research based services required for 650+ Pharmaceutical, Chemicals, Phytochemicals, Herbal Formulations and Food manufacturers globally.
Our 85,000+ square feet state-of-the-art Research & Testing facility is equipped with cutting-edge instrumentation and experienced team of 150+ highly skilled scientists, researchers, and professionals who are passionate about pushing the boundaries of knowledge and delivering exceptional results.
Our testing facility is accredited by a different accreditation like 9 National Accreditations including FDCA, FDCA-GLP, CCSEA, NABL, AYUSH, DSIR, CDSCO, FDCA-Cosmetic and CIBRC, as well as 5 International Accreditations including ISO 9001:2015, OECD-GLP, AAALAC, DUNS and USFDA.
We are providing regulatory testing and research based services to 650+ Pharmaceuticals clients globally for your NDA, ANDA, USFDA QC Release & DMF filing and 350+Medical Device companies globally.